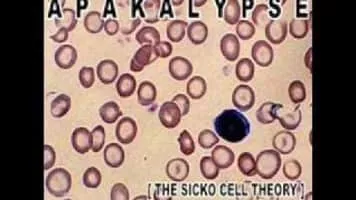

Apakalypse
|
Use attributes for filter !
|
| Genres | Hip-Hop/Rap |
|---|
| Albums | Garage Days, Vol. 1 |
|---|
| Walking Coma |
|---|
| Trust In Self |
|---|
|
FLorida Man
|
|---|
| Supreme Intoxication |
|---|
| Record labels |
E. S. F Records
|
|---|
|
E. S. F/ Templars of Hip Hop
|
|---|
|
E.S.F / Edk Records
|
|---|
|
E.S.F/ Edk Nod Records
|
|---|
| Songs | Chasing Interstellar AnunnakiTrust In Self · 2010 Shinobi ChroniclesThe Wonder Years (Beat Tape) · 2020 The GODz Strike BackThe GODz Strike Back · 2021 View 25+ more |
|---|
| List | Chasing Interstellar AnunnakiTrust In Self · 2010 |
|---|
| Shinobi ChroniclesThe Wonder Years (Beat Tape) · 2020 |
|---|
| The GODz Strike BackThe GODz Strike Back · 2021 |
|---|
| Date of Reg. | |
|---|
| Date of Upd. | |
|---|
| ID | 980932 |
|---|
Send edit request
Related searches
apakalypse florida man